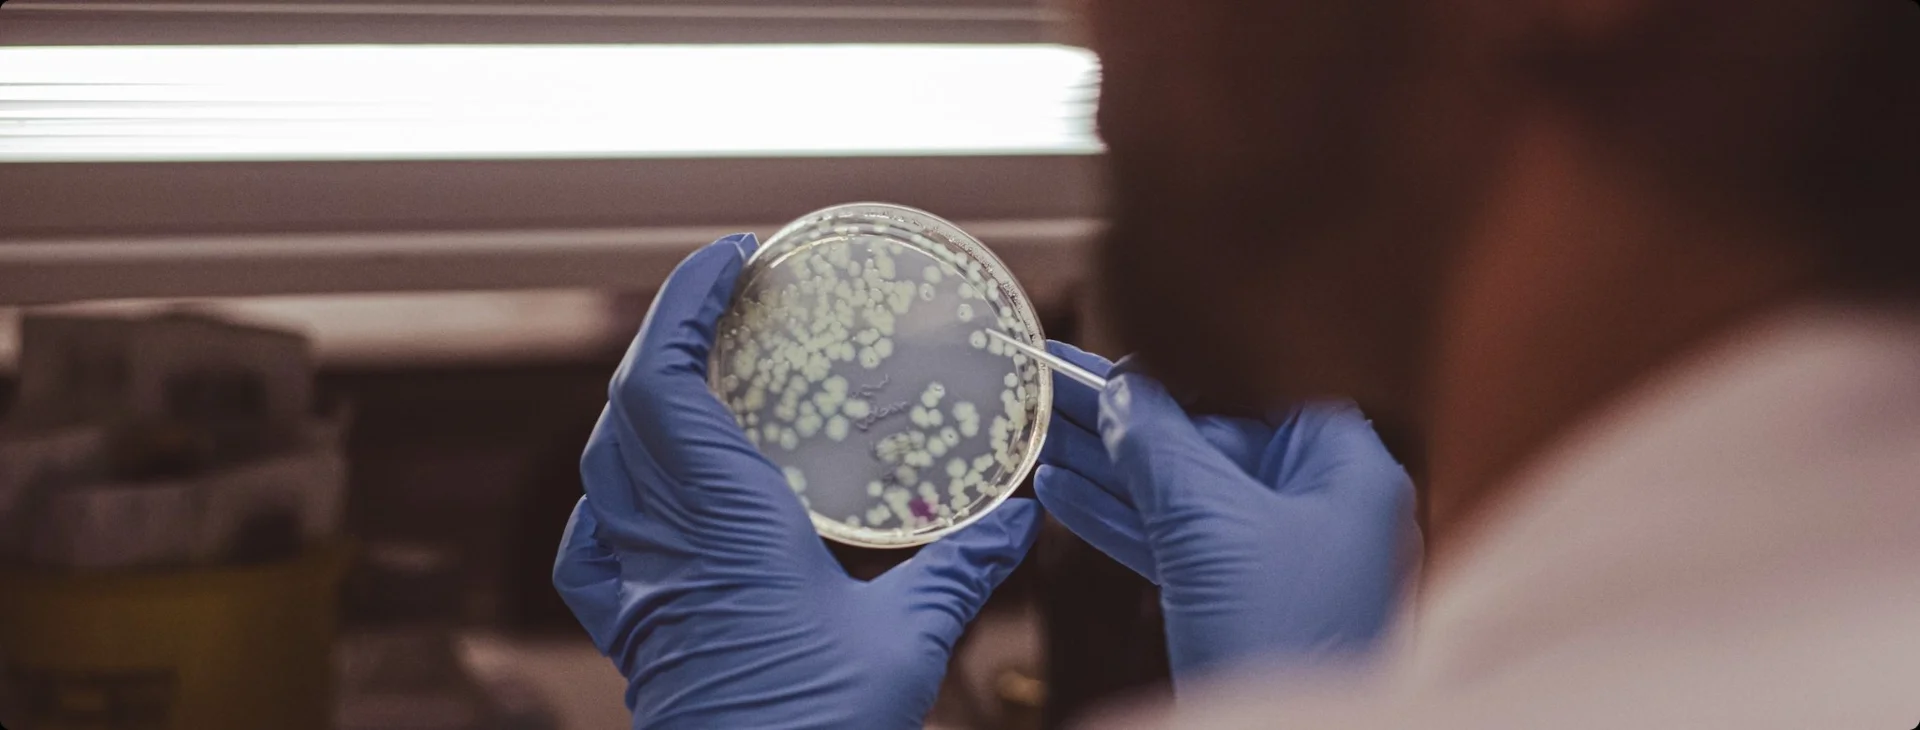

Presentació
Unitat encarregada de la negociació i formalització dels contractes dels estudis clínics que es duguin a terme a les Balears, a través de la comunicació amb les diferents parts implicades (promotors, investigadors principals, coordinadors/es, serveis implicats, etc.).
A través de quines plataformes es duen assaigs clínics a l’IdISBa?
Assaigs clínics realitzats per l’IdISBa
La gestió econòmico administrativa de l'execució de tots els estudis clínics desenvolupats a les Balears es realitzarà des d'aquesta mateixa unitat.
En cada contracte es definirà la participació dels equips de recerca, plataformes, unitats de suport, serveis col·laboradors, etc.
Centres a les Balears:
- Hospital Universitari Son Espases
- Hospital Universitari Son Llàtzer
- Hospital Comarcal d'Inca
- Hospital de Manacor
- Hospital Can Misses
- Hospital General Mateu Orfila
- i tots els centres d'Atenció Primària de les Balears.

Gestió Idoneïtat de les instal·lacions
Per posar en marxa un assaig clínic és necessari sol·licitar la signatura de la idoneïtat de les instal·lacions enviant un correu electrònic a la Unitat d'Assaigs Clínics de l'IdISBa (idisba.ensayos@idisba.es) amb les dades bàsiques de l'estudi (Codi, EUDRACT, Investigador Principal i Servei de Realització) i la documentació següent:
- Protocol de l'Estudi
- Sinopsi en castellà
- Memòria Econòmica General
- Model Idoneïtat Instal·lacions o Annex IV AEMPS emplenat
Després de la recepció de la sol·licitud, la Unitat d'Assaigs Clínics tramitarà la signatura del document per la Gerència del Centre.
La Unitat d'Assaigs Clínics enviarà el document signat al Promotor o CRO al correu electrònic sol·licitant i podrà iniciar-se la gestió del contracte i la memòria econòmica.
Gestió del contracte d'Assaig Clínic
El promotor haurà d'enviar emplenat el Model de contracte corresponent, juntament amb la documentació necessària per a cada tipus d'estudi, al correu idisba.ensayos@idisba.es
Documentació necessària
Per formalitzar contractes d'assaigs clínics amb medicament / recerca clínica amb producte sanitari:
- Protocol de l'Assaig Clínic
- Aprovació per l'AEMPS
- Aprovació del CEIm de referència
- Pòlissa d'assegurança
- Memòria econòmica amb desglossament detallat de les visites i proves a realitzar
- Document de delegació de funcions/responsabilitats legitimat notarialment o poders per signar en representació del promotor (en cas que signi la CRO en nom del promotor)
- Dades fiscals per a l'emissió de les factures
Per formalitzar contractes d'estudis observacionals amb medicament o estudis post-comercialització amb producte sanitari:
- Protocol
- Dictamen favorable del CEIm acreditat
- Memòria econòmica presentada al CEIm
- Document de delegació de responsabilitats (en cas que signi la CRO en nom del promotor)
- Dades fiscals per a l'emissió de les factures